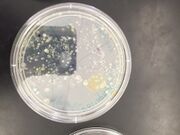

Uploads by Alison M. Taylor
From OpenWetWare
Jump to navigationJump to search
This special page shows all uploaded files.
| Date | Name | Thumbnail | Size | Description |
|---|---|---|---|---|
| 21:33, 15 March 2016 | FixedFishAMT.jpeg (file) |  |
61 KB | |
| 17:36, 28 February 2016 | Zebra1AMT.jpg (file) |  |
49 KB | |
| 20:12, 20 February 2016 | EmbryoCompareAMT.jpg (file) |  |
40 KB | |
| 17:46, 13 February 2016 | FoodWebAMT.jpg (file) |  |
39 KB | |
| 17:01, 13 February 2016 | BerleseFunnelAMT.jpg (file) |  |
29 KB | |
| 22:23, 6 February 2016 | PlantTableAMT.jpg (file) |  |
36 KB | |
| 22:01, 6 February 2016 | MushroomDrawingAMT.jpg (file) |  |
40 KB | |
| 21:47, 6 February 2016 | PlantSamplesAMT.jpg (file) |  |
119 KB | |
| 16:13, 30 January 2016 | CellDescriptionsAMT.jpeg (file) |  |
35 KB | |
| 16:13, 30 January 2016 | CellDataAMT.jpeg (file) |  |
20 KB | |
| 00:27, 29 January 2016 | AgarPlate5AMT.jpeg (file) | |
94 KB | |
| 00:27, 29 January 2016 | AgarPlate4AMT.jpeg (file) |  |
92 KB | |
| 00:27, 29 January 2016 | AgarPlate3AMT.jpeg (file) |  |
79 KB | |
| 00:26, 29 January 2016 | AgarPlate2AMT.jpeg (file) |  |
67 KB | |
| 00:26, 29 January 2016 | AgarPlate1AMT.jpeg (file) |  |
79 KB | |
| 23:55, 28 January 2016 | SerialDilutionResultsAMT.jpeg (file) |  |
38 KB | |
| 00:31, 23 January 2016 | ProtistsObservedAMT.jpg (file) |  |
83 KB | |
| 00:13, 23 January 2016 | SerialDilutionAMT.jpg (file) |  |
40 KB | |
| 21:49, 17 January 2016 | Transect2AerialDraw.jpg (file) |  |
182 KB | |
| 19:52, 16 January 2016 | Transect2PanoramicView.jpg (file) | 146 KB | ||
| 19:51, 16 January 2016 | Transect2AerialView.jpg (file) |  |
493 KB |